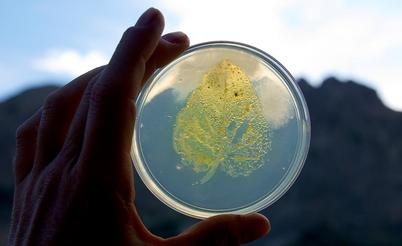
A hand holds up an agar petri dish to the sky with mountains in the background. Growing on the agar are microbes from the impression of a leaf where you can see with high fidelity the shape and veins of the original leaf just from the microbes growing on the plate.

We study the genetic and molecular basis of adaptation that arises from biotic interactions. These adaptations evolve through simple adaptive tracking of one species by another or through coevolution. Coevolution occurs when species exert reciprocal natural selection on each other such that adaptation is interdependent. The process of coevolution can unfold diffusely within guilds of species, between species pairs, and between loci. It is hypothesized to have driven much of the diversification of life. Therefore, understanding the mechanistic basis of coevolution, from genes to phenotypes to fitness, is of central importance in biology.
We mostly focus on host-parasite interactions and use plants as model hosts and herbivorous insects and plant pathogens as parasites. Often, our work focuses on toxins produced by plants and insects used in defense against enemies. Since 2007, we have studied the evolution of herbivory and host plant specialization in the drosophilid fly Scaptomyza flava, an herbivore of mustards like the genetic model plant Arabidopsis thaliana. This fly species is phylogenetically nested in the paraphyletic Drosophila subgenus. This means that in essence, S. flava is a Drosophila that attacks Arabidopsis. We have studied how this fly lineage evolved a plant-penetrating ovipositor, how it detects and uses volatile mustard oils to find host plants, how it detoxifies mustard oils, and how its interactions with bacteria influence its life history. We are also using this system to study how fly populations adapt to different host plant species in single host plant and mixed host plant environments and how functional genetic variation can be maintained by spatially varying natural selection through such heterogeneous environments.
We often rely on genome editing to study the molecular mechanisms of chemical co-evolution between species. Three case studies illustrate how. The first case traced the origins of cardiac glycoside resistance in monarch butterflies, which sequester these toxins in defense against birds, and how some monarch-eating birds evolved to resist those toxins too. The second case focused on distinct waves of neurotoxic terpenoid diversification in plants over the past 400 million years, along with co-diversification of herbivorous insects and their predators that evolved resistant GABA receptors. The third case illuminated how apoptotic toxin-encoding genes in bacteria were captured by Drosophila species through horizontal gene transfer, became integrated into the fly innate immune system, and are used as defensive weapons against parasitoid wasps.
Finally, our research on Broad-tailed hummingbirds and their nectar plants focuses on the genome-wide architecture associated with foraging traits like bill size and shape and arrival time at the breeding grounds. This research dovetails with Noah’s long-standing interest in coevolution between birds and other species.
More than anything else, the particular research interests of each lab member determine our lab’s trajectory.

You must be logged in to post a comment.